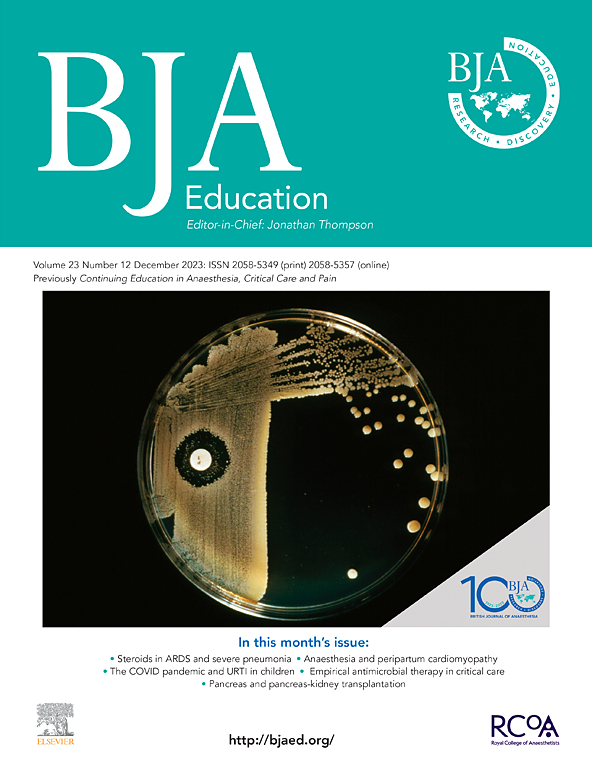
Go to journal home page - BJA Education

Editor-in-Chief
View full editorial boardArticles
More from BJA Education
Special issues and article collections
Boyhood in 21st Century Educative Contexts
Edited by
Garth
Stahl, Amanda
Keddie, Laura
Scholes
3 July 2024
Rethinking educational practices and responsibilities in the light of digitalisation
Edited by
Lisa
Paleczek, Eva
Pölzl-Stefanec,
Kathrin Otrel-Cass
15 September 2022
Neoliberalism, Education Inequity and Improvement
Edited by
Tien-Hui
Chiang, Alison
MacKenzie
22 July 2022
Motivation of Higher Education Faculty: Theoretical Approaches, Empirical Evidence, and Future Directions
Edited by
Martin
Daumiller, Robert
Stupnisky,
Stefan Janke
22 July 2022
Partner journals
The BJA Education is a companion title of the BJA Education is an open access, peer-reviewed journal which draws contributions from a wide community of international and interdisciplinary researchers …
View full aims & scopeRelated journals
Print ISSN: 0883-0355
Online ISSN: 1873-538X
Copyright © 2024 Elsevier Ltd. All rights reserved